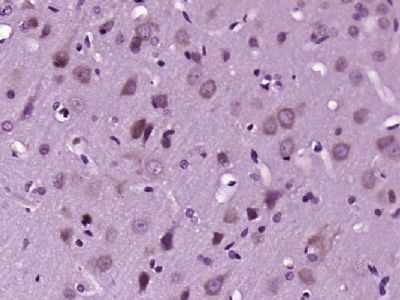
MARK2丝氨酸/苏氨酸蛋白激酶MARK2抗体

相关产品推荐更多 >
万千商家帮你免费找货
0 人在求购买到急需产品
- 详细信息
- 技术资料
- 供应商:
上海联迈生物工程有限公司
- 库存:
大量
- 目录编号:
LM-5741R
- 克隆性:
多克隆
- 抗原来源:
Rabbit
- 保质期:
1年
- 抗体英文名:
MARK2
- 抗体名:
丝氨酸/苏氨酸蛋白激酶MARK2抗体
- 宿主:
Rabbit
- 适应物种:
Human, Mouse, Rat, Dog, Pig, Cow, Horse, Sheep,
- 免疫原:
KLH conjugated synthetic peptide derived from human MARK2 (236-285aa):201-300/788
- 亚型:
IgG
- 形态:
Lyophilized or Liquid
- 应用范围:
ELISA=1:500-1000 IHC-P=1:400-800 IHC-F=1:400-800 IF=1:100-500 (石蜡切片需做抗原修复)
- 浓度:
1mg/ml
- 保存条件:
Store at -20 °C
- 规格:
100ul 200ul
MARK2丝氨酸/苏氨酸蛋白激酶MARK2抗体
| 英文名称 | MARK2 |
| 中文名称 | 丝氨酸/苏氨酸蛋白激酶MARK2抗体 |
| 别 名 | ELKL motif kinase 1; ELKL motif kinase; EMK-1; EMK1; MAP/microtubule affinity regulating kinase 2; MAP/microtubule affinity-regulating kinase 2; Mark2; MARK2_HUMAN; PAR1 homolog; Serine/threonine protein kinase MARK2; Serine/threonine-protein kinase MARK2. |
| 规格价格 | 100ul/1380元 购买 200ul/2200元 购买 大包装/询价 |
| 说 明 书 | 100ul 200ul |
| 研究领域 | 免疫学 信号转导 激酶和磷酸酶 |
| 抗体来源 | Rabbit |
| 克隆类型 | Polyclonal |
| 交叉反应 | Human, Mouse, Rat, Dog, Pig, Cow, Horse, Sheep, |
| 产品应用 | ELISA=1:500-1000 IHC-P=1:400-800 IHC-F=1:400-800 IF=1:100-500 (石蜡切片需做抗原修复) not yet tested in other applications. optimal dilutions/concentrations should be determined by the end user. |
| 分 子 量 | 88kDa |
| 细胞定位 | 细胞浆 细胞膜 |
| 性 状 | Lyophilized or Liquid |
| 浓 度 | 1mg/ml |
| 免 疫 原 | KLH conjugated synthetic peptide derived from human MARK2 (236-285aa):201-300/788 |
| 亚 型 | IgG |
| 纯化方法 | affinity purified by Protein A |
| 储 存 液 | 0.01M TBS(pH7.4) with 1% BSA, 0.03% Proclin300 and 50% Glycerol. |
| 保存条件 | Store at -20 °C for one year. Avoid repeated freeze/thaw cycles. The lyophilized antibody is stable at room temperature for at least one month and for greater than a year when kept at -20°C. When reconstituted in sterile pH 7.4 0.01M PBS or diluent of antibody the antibody is stable for at least two weeks at 2-4 °C. |
| PubMed | PubMed |
| 产品介绍 | background: This gene encodes a member of the Par-1 family of serine/threonine protein kinases. The protein is an important regulator of cell polarity in epithelial and neuronal cells, and also controls the stability of microtubules through phosphorylation and inactivation of several microtubule-associating proteins. The protein localizes to cell membranes. Multiple transcript variants encoding different isoforms have been found for this gene. [provided by RefSeq, Jul 2009]. Function: Serine/threonine-protein kinase involved in cell polarity and microtubule dynamics regulation. Phosphorylates CRTC2/TORC2, DCX, HDAC7, KIF13B, MAP2, MAP4, MAPT/TAU, and RAB11FIP2. Plays a key role in cell polarity by phosphorylating the microtubule-associated proteins MAP2, MAP4 and MAPT/TAU at KXGS motifs, causing detachment from microtubules, and their disassembly. Regulates epithelial cell polarity by phosphorylating RAB11FIP2. Involved in the regulation of neuronal migration through its dual activities in regulating cellular polarity and microtubule dynamics, possibly by phosphorylating and regulating DCX. Regulates axogenesis by phosphorylating KIF13B, promoting interaction between KIF13B and 14-3-3 and inhibiting microtubule-dependent accumulation of KIF13B. Also required for neurite outgrowth and establishment of neuronal polarity. Regulates localization and activity of some histone deacetylases by mediating phosphorylation of HDAC7, promoting subsequent interaction between HDAC7 and 14-3-3 and export from the nucleus. Also acts as a positive regulator of the Wnt signaling pathway, probably by mediating phosphorylation of dishevelled proteins (DVL1, DVL2 and/or DVL3). Modulates the developmental decision to build a columnar versus a hepatic epithelial cell apparently by promoting a switch from a direct to a transcytotic mode of apical protein delivery. Essential for the asymmetric development of membrane domains of polarized epithelial cells. Subunit: Homodimer. Interacts with PAK7/PAK5; leading to inhibit the protein kinase activity (By similarity). Interacts (when phosphorylated at Thr-596) with YWHAZ. In case of infection, interacts with H.pylori CagA, leading to inhibit kinase activity and junctional and polarity defects. Subcellular Location: Cell membrane; Peripheral membrane protein. Cytoplasm. Note=Phosphorylation at Thr-596 by PRKCZ/aPKC and subsequent interaction with 14-3-3 protein YWHAZ promotes relocation from the cell membrane to the cytoplasm. Tissue Specificity: High levels of expression in heart, brain, skeletal muscle and pancreas, lower levels observed in lung, liver and kidney. Post-translational modifications: Autophosphorylated. Phosphorylated at Thr-208 by STK11/LKB1 in complex with STE20-related adapter-alpha (STRADA) pseudo kinase and CAB39. Phosphorylation at Thr-208 by TAOK1 activates the kinase activity, leading to phosphorylation and detachment of MAPT/TAU from microtubules. Phosphorylation at Ser-212 by GSK3-beta (GSK3B) inhibits the kinase activity. Phosphorylation by CaMK1 promotes activity and is required to promote neurite outgrowth. Phosphorylation at Thr-596 by PRKCZ/aPKC in polarized epithelial cells inhibits the kinase activity and promotes binding to 14-3-3 protein YWHAZ, leading to relocation from cell membrane to cytoplasm. Similarity: Belongs to the protein kinase superfamily. CAMK Ser/Thr protein kinase family. SNF1 subfamily. Contains 1 KA1 (kinase-associated) domain. Contains 1 protein kinase domain. Contains 1 UBA domain. SWISS: Q7KZI7 Gene ID: 2011 Database links: Entrez Gene: 2011 Human Entrez Gene: 13728 Mouse Entrez Gene: 60328 Rat Omim: 600526 Human SwissProt: Q7KZI7 Human SwissProt: Q05512 Mouse SwissProt: O08679 Rat Unigene: 567261 Human Unigene: 258986 Mouse Unigene: 42926 Rat Important Note: This product as supplied is intended for research use only, not for use in human, therapeutic or diagnostic applications. |
| 产品图片 | ![]() Paraformaldehyde-fixed, paraffin embedded (Rat brain); Antigen retrieval by boiling in sodium citrate buffer (pH6.0) for 15min; Block endogenous peroxidase by 3% hydrogen peroxide for 20 minutes; Blocking buffer (normal goat serum) at 37°C for 30min; Antibody incubation with (MARK2) Polyclonal Antibody, Unconjugated (bs-5741R) at 1:400 overnight at 4°C, followed by a conjugated secondary antibody (sp-0023) for 20 minutes and DAB staining. ![]() Tissue/cell: rat brain tissue; 4% Paraformaldehyde-fixed and paraffin-embedded; Antigen retrieval: citrate buffer ( 0.01M, pH 6.0 ), Boiling bathing for 15min; Block endogenous peroxidase by 3% Hydrogen peroxide for 30min; Blocking buffer (normal goat serum,C-0005) at 37℃ for 20 min; Incubation: Anti-MARK2 Polyclonal Antibody, Unconjugated(bs-5741R) 1:200, overnight at 4°C, followed by conjugation to the secondary antibody(SP-0023) and DAB(C-0010) staining ![]() Tissue/cell: rat lymph node;4% Paraformaldehyde-fixed and paraffin-embedded; Antigen retrieval: citrate buffer ( 0.01M, pH 6.0 ), Boiling bathing for 15min; Blocking buffer (normal goat serum,C-0005) at 37℃ for 20 min; Incubation: Anti-MARK2 Polyclonal Antibody, Unconjugated(bs-5741R) 1:200, overnight at 4°C; The secondary antibody was Goat Anti-Rabbit IgG, Cy3 conjugated(bs-0295G-Cy3)used at 1:200 dilution for 40 minutes at 37°C. DAPI(5ug/ml,blue,C-0033) was used to stain the cell nuclei |
风险提示:丁香通仅作为第三方平台,为商家信息发布提供平台空间。用户咨询产品时请注意保护个人信息及财产安全,合理判断,谨慎选购商品,商家和用户对交易行为负责。对于医疗器械类产品,请先查证核实企业经营资质和医疗器械产品注册证情况。
技术资料暂无技术资料 索取技术资料
MARK2丝氨酸/苏氨酸蛋白激酶MARK2抗体
¥1380 - 2200